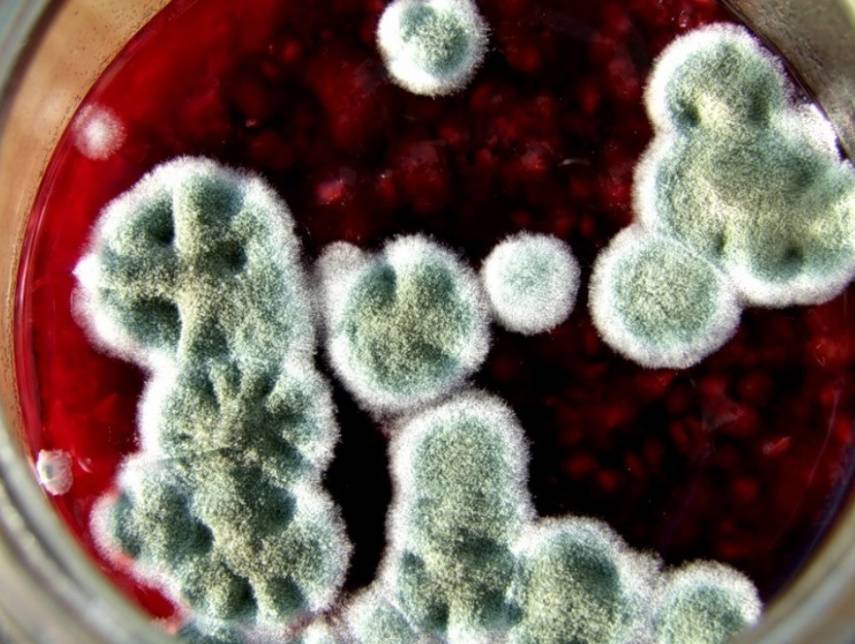

Как распознать плесень при изготовлении домашнего вина
Многие неопытные виноделы предполагают, что появление плесени на вине – вполне нормальное событие. Действительно, всем известно, что брожение вызывается микроорганизмами, также называемыми дрожжами. В чем же отличие плесени от них и должна ли она вообще быть на вине?
Разумеется ответ на этот вопрос отрицателен. Присутствие плесени в винных напитках не только недопустимо, но и по-настоящему опасно. Чтобы понять в чем разница между винными дрожжами и этой вредной субстанцией, давайте рассмотрим сам принцип их деятельности.
Попадая в благоприятную среду дрожжи размножаются и преобразуют ряд веществ в углекислый газ и спирт, благодаря чему вино и получает определенный градус. Плесень же представляет собой набор каких-либо грибков, которые перерабатывают те же вещества в углекислый газ и воду.
Именно поэтому появления плесени нужно избегать всеми силами, однако если это все же произошло, нужно уметь ее распознать.
Как распознать плесень в домашнем вине
Образование
Во всех рецептурах изготовления вина указывается, что одной из важнейших задач, стоящих перед виноделом, является слежение за суслом. Действительно, именно начальная стадия появления плесени считается тем временем, когда благородный напиток еще можно «спасти».
Разрастание
Следующим этапом развития плесени является увеличение колонии грибков. На этой стадии белесая пленка уплотняется и становится толще. На поверхности сусла наблюдаются своего рода плесневелые центры, которые отличаются по цвету и структуре от всей остальной колонии грибков.
Считается, что на этом этапе вино также можно избавить от плесени, однако мы все же не рекомендуем этого делать. Дело здесь в том, что частично грибки могут попадать в нижние слои сусла. Кроме того, вкус вина на этом этапе уже меняется в худшую сторону.
Поражение сусла
Заключительным этапом разрастания плесени является выпадение колоний грибов в осадок сусла. Масса их становится слишком большой и они опускаются на дно. Обычно к этому моменту от винного напитка практически ничего не остается, а содержимое емкости представляет собой смесь грибков и воды. Естественно, такое «вино» восстановить уже точно нельзя.
Как видите, даже в том случае если вино зацвело, у вас есть некоторое время для того, чтобы избавиться от болезнетворных грибков. Однако здесь возникает резонный вопрос, почему вообще на сусле образуется плесень? На самом деле причин может быть несколько.
Плесень в сусле вина
Самой распространенной из них считается недостаточная дезинфекция емкостей, используемых для виноделия. Загрязненная тара уже содержит споры грибков, которые начинают массово размножаться в питательной среде – сусле. Также причиной может стать нетщательный перебор сырья. Гниение ягод и фруктов всегда сопровождается размножением все тех же грибков, что и составляют плесень. Попадая в сусло, они концентрируются в верхней части, а затем поражают и весь напиток. Относительно низкая температура является неблагоприятной для винных дрожжей, однако она помогает развитию плесени
Именно поэтому важно следить, чтобы сусло на этапе брожения находилось в теплом месте. Кислотность сусла также играет свою роль
Кислая среда не дает колонии грибков разрастаться, при этом практически никак не влияет на деятельность дрожжей. Спирт, который выделяется дрожжами при брожении, является губительным для грибков и не дает плесени появиться. Если же содержание его в сусле крайне низко, это зачастую приводит к цветению жидкости. Отсутствие гидрозатвора или резиновой перчатки на горлышке емкости с суслом также может стать причиной появления плесени. Споры грибков беспрепятственно попадают на поверхность сусла и разрастаются.
Как распознать грибок при изготовлении домашнего вина
Распознать, что приготовленный напиток заражен грибком, легко. Появление колоний, прежде чего, характеризуется белым налетом. Есть три этапа развития патогенных организмов, на некоторых спасти домашнее вино уже нельзя.
Как выглядит грибок на вине.

Грибок на вине

Грибок
Этапы заражения и их характеристики:
- На первом этапе можно заметить появление белой пленки. Полупрозрачный налет остается на поверхности напитка.
- Далее пленка обретает темный цвет. Начинает расти грибной нарост.
- Заключительный этап – формируются хлопья, выпадают на дно. В этот момент цвель необратимо портит алкоголь.
Если вино поразила пленка, то его можно спасти без потери качества. На втором этапе появляется риск, что вкус и аромат напитка будут неприятными, даже если предпринять все меры. Если хлопья выпали на дно, то в бутылке уже не винный напиток, а вода со слабым неприятным запахом.

Какие еще «симптомы» болезни вина появляются:
- Винный спирт начинает преобразовываться в уксус, появляется характерный запах.
- Появился жирный налет, сусло становится тягучим.
- Напиток прокис, появился неприятный запах.
- Появился вкус горечи.
Очистка домашнего вина: как правильно удалять плесень?
Что делать если на вине появилась плесень? В домашнем виноделии образование плесени на напитках случается довольно часто. Это означает, что в процессе приготовления вина была нарушена технология, или не соблюдался температурный режим. Если Вы вовремя заметили это неприятное явление, то вино удастся спасти. Из этой статьи Вы узнаете, что собой представляет плесень, какие меры профилактики существуют, также прочитаете о способах её удаления.
Винная плесень
Другое название этого явления, которое поражает домашнее вино – цвель. По своей сути винная плесень – это грибок, который развивается в благоприятных условиях и заражает сусло. Плесень воздействует на органические соединения, перерабатывает их в воду и углекислый газ. В результате такого взаимодействия вино портится.
Развитие винной плесени состоит из двух этапов. Если Вы заметили её возникновение лишь на заключительной стадии, то вино придётся вылить. Первые два этапа развития при своевременно принятых мерах можно устранить. Но давайте обо всём по порядку.
В начале своей вредоносной деятельности винная плесень выглядит, как тонкая плёнка на поверхности вина. Затем структура её уплотняется, и она начинает прилипать к стенкам бродильной ёмкости. Следующий этап развития грибка более заметен. Тонкая плёнка превращается в толстую, морщинистую массу. У вина появляется резкий и неприятный запах. В своей последней стадии, плесень опускается на дно и продолжает развиваться.
Благоприятные условия для возникновения и развития винной плесени
Как и любой грибок, винная плесень развивается только в благоприятной среде. Вот наиболее вероятные условия для её образования и процветания:
- Несоблюдение стерильности при производстве вина. В результате несоблюдения гигиенических норм, в сусло может попасть возбудитель, который и спровоцирует развитие плесени.
- Доступ кислорода к суслу. В воздухе содержится масса бактерий, которые могут являться разносчиками плесени.
- Низкая температура и высокая влажность. Если температура брожения равняется 20-28 градусам Цельсия, а влажность превышает 85%, считайте, что для плесени созданы все условия.
- Низкое содержание спирта. Хорошо размножается грибок при содержании спирта менее 12%.
- Низкий уровень кислотности. Замечено, что красные сорта вин более подвержены плесени, чем белые.
Профилактика возникновения плесени в вине
- Необходимо тщательно мыть руки при работе с суслом. Кроме того, рекомендуется обрабатывать все инструменты, сосуды, крышки и другие приспособления. Стоит более внимательно относиться к сырью. Ягоды для вина нужно тщательно мыть и перебирать. Основным источником заражения являются подгнившие плоды.
- Если для сусла используются целые плоды (метод Мезге), то нужно регулярно перемешивать всплывающую массу.
- Не стоит усердствовать при разбавлении сусла водой. Это снижает уровень кислотности. Если этот показатель падает, можно его повысить лимонной кислотой.
- Использовать только герметичные бродильные ёмкости, оборудованные гидрозатвором. Это снизит вероятность контакта сусла с кислородом.
- Хранить готовое вино рекомендуется при температуре не более 46 градусов Цельсия.
Как удалить плесень с вина?
Как уже упоминалось, вступление плесени в заключительную стадию развития имеет необратимый характер. Это вино спасти уже не получится, а вот для остальных этапов развития будут актуальны следующие меры:
Переливание. В плёнке проделывается небольшое отверстие, в которое вставляют резиновый шланг. Через него и перекачивают непораженное грибком вино в другую тару. Главное, следить за тем, чтобы плесень не попала в шланг.
Стерилизация. Для этого сусло нагревают до 75 градусов Цельсия, затем варят около двух минут. После чего закрывают герметичной крышкой и остужают до комнатной температуры.
Стабилизация. Это способ заключается в повторном брожении вина. Сделать это можно добавив сахар или сок. Можно добавить винный спирт, это повысит крепость сусла.
В компании «Алкоприбор» Вы сможете найти не только полезное и удобное оборудование для успешного виноделия в домашних условиях, но и будете первыми узнавать важную информацию о проверенных технологиях производства домашних напитков.
Боремся с плесенью на домашнем вине

Винная цвель (плесень) является колонией пленчатых грибков, поражающие при благоприятных условиях сусло, данная плесень перерабатывает питательные органические соединения, которые содержатся в вине, такие как сахар, спирт, кислоту на углекислый газ, воду и прочие вещества, которые портят вкус вина.
Признаки винной плесени
Сперва на поверхности вина появляется бесцветная тонкая либо же гладкая белая пленка, которая разрастается со временем, уплотняется и липнет к стенкам емкости. После этого этот шар плесени в разы темнеет, становится морщинистым и толстым. Вино приобретает неприятный запах тухлой воды. А уже на последнем этапе плесневые грибки опускаются на дно, что приводит к бесспорной порче напитка.
Появление плесени: условия
- Плохая стерильность сырья, емкостей инструментов, что приводит к попаданию в сусло возбудителя;
- попадание кислорода в вино;
- температура хранения вина 22-28°C;
- высокая влажность (свыше 85%);
- Количество спирта менее 12%;
- Кислотность сусла низкая, таким образом белые вина заражаются быстрее чем красные.
Исправление зараженного вина

От самой пленки избавляются следующим образом. Нужно, наоборот, с помощью шланга, который опущен в бутыль сквозь налет плесени долить не зараженное вино, это нужно делать до тех пор, пока оно не польется через край, выталкивая за собой плесень. После чего необходимо обработать слитое вино, есть несколько вариантов как можно это сделать.
Методы удаления плесени
- Пастеризация. Вино необходимо прогреть при температуре 70°С от нескольких минут до часу, в зависимости от объема сосудов, бутылка 0,5 л – около двух минут, 20 л и более нужно прогревать до часа-полутора. После этого нужно отправить вино на хранение.
- Обработка серой.Серная кислота – яд для винной плесени. Данный метод обработки подразумевает окуривания чистых сосудов серными фитилями либо же добавления ее непосредственно в вино в жидком виде.
- Стабилизация.Необходимо поднять градус напитка добавив в него винный спирт.
Также вино можно заново сбродить, добавив свежий сок и сахар.
Предотвращаем появления плесени
Для этого необходимо избегать попадания в сусло спор грибков.
- Тщательное стерилизовать инструменты, приборы, пробки, которые участвуют в процессе приготовления напитка. По мимо этого неотъёмным условием работы с вином является наличие чистых рук.
- Нельзя использовать для приготовления напитка плесневелых или гнилых ягод. Если вы приняли решение не отделять мякоть и кожицу от сока, то есть брожение создать на мезге, тогда нужно перемешивать так верхний слой, чтобы не допускать длительного контакта кислорода и мезги.
- Чтобы поддержать нужную кислотность не нужно сильно разбавлять сусло водой. По мере необходимости можно добавлять лимонную кислоту.
- Устраняйте возможности проникновения в напиток кислорода, для этого устанавливайте гидрозатвор и убедитесь в герметичности.
- Храните напиток после брожения при температуре 10-16 С.
Но в случае, когда вино заражается плесневыми грибками, на начальной стадии приготовления, то вылечить его уже нельзя.
Эта статья про: “вино покрылось белой пленкой что делать”.
- Как правильно приготовить виноградное вино? – как делать правильно виноградное вино
- Вино Изабелла: рецепты приготовления сухого вина из винограда в домашних условиях – как делать вино в домашних условиях из винограда изабелла
- Вино из яблок – 4 рецепта в домашних условиях – как делать вино из яблок в домашних условиях рецепт
- Ответы: как сделать вино из винограда в домашних условиях? – как правильно делать вино из винограда в домашних условиях
- Виноградное вино в домашних условиях – простой рецепт – как делать домашнее виноградное вино самый простой способ
- Рецепт вина из черноплодной рябины домашнего приготовления – как делать вино из черноплодной рябины в домашних условиях
- Домашнее вино из зеленого крыжовника – пошаговый рецепт – как делать вино из крыжовника
- Виноградное вино в домашних условиях – как правильно делать виноградное вино в домашних условиях
- Что делать, если вино плохо играет: причины и их решение – что делать если вино не играет
- Вино из шелковицы в домашних условиях – пошаговый рецепт – как делать вино из шелковицы в домашних условиях
← Как правильно заваривать чай? — как правильно завариватьКак сварить абрикосовый компот — способы сделать заготовку на зиму и быстрый рецепт в кастрюле и в мультиварке — как варить компот из абрикосов →
Вино покрывается плесенью, что делать при появлении грибка на домашнем вине
Вы из года в год готовите вино в домашних условиях или только первый раз пробуете? Смущает новообразование в виде пленки на поверхности вина? Подозреваете, что вино покрывается плесенью? Давайте разберемся.
Вино приготовлено по той же технологии что и ранее готовили, из винограда, который вы знаете, а плесень появилась. Что делать и как бороться?
Обнаружение появления грибка плесени на домашнем вине
В один прекрасный день, ничего не подозревая, вы замечаете, что ваше вино покрывается плесенью и обнаруживаете поверх него пленку в виде плесени или цвели — грибок поразивший сусло с вашим напитком. Появление грибка начинается с тонкой пленки на поверхности. Если, вы обнаружили данную неприятность на первых этапах, значит, вино еще можно спасти. В случае обнаружения большого скопления грибковых пятен или плесень полностью покрыла поверхность домашнего вина, начала оседать на стенках сусла и опадать на дно, будет свидетельствовать о том, что сусло, скорее всего, придется вылить. Хотя, существует вариант спасения, перегонка испортившегося вина в спирт.
Вино покрывается плесенью, в чем причина возникновения
После сбора плодов или ягод, перед тем как делать домашнее вино, их тщательно перебирают от гнилых и заплесневелых. Но не моют, дабы сохранить винные дрожжи, которые содержатся на поверхности.
- Качество и мытье сырья. В момент переборки, нужно внимательно следить, чтобы плохое сырье не попало в емкость. В противном случае можно испортить всю партию будущего напитка. Довольно часто, для понижения кислотности вина, добавляют воду, но мало кто знает, если добавить слишком много воды, кислотность понизится и это может привести к образованию грибка и вино покрывается плесенью. Нормой кислотности считается от 3 до 8 г/дм3.
- Герметизация емкости для брожения. В момент брожения, горловину сусла закрывают перчаткой либо же гидрозатвором. Лучше, конечно гидрозатвор. Нарушение герметизации может привести к попаданию в емкость кислорода, который будет контактировать с суслом и привести к скисанию или возникновению плесни на домашнем вине.
- Недостаток сахара в плодах и ягодах. Ягоды могут содержать малое количество сахара, а это не даст будущему вину брожения и крепости, что может привести к появлению плесени.
- В сусле большое количество свободного места
Еще одной из причин может быть не полное заполнение емкости, вследствие чего появляется вероятность образования в пустом пространстве пленчатых дрожжей.
Устранение возникшей плесени на поверхности домашнего вина
Если беда уже произошла, будем исправлять и лечить напиток. На ранних стадиях, когда домашнее вино покрывается плесенью в виде образования пленки, необходимо в пленке проделать небольшое пространство и вставить чистую трубочку (можно взять капельницу), далее все аккуратно слить в чистую емкость. Но следует следить, чтобы осадок из сусла и верхнее образование плесени не попали в новую емкость, иначе можно будет окончательно все испортить. Пусть лучше останется небольшое количество в бутыле. После чего следует слить осадок и плесень.
Второй вариант более или менее хлопотный, если у вас осталась винная заготовка в бутылочке, следует также проделать отверстие в цвели и аккуратно через трубочку доливать в емкость не зараженное вино, до тех пор, пока оно не начнет переливаться через горловину сусла.
Следующий вариант не слишком распространен, но тоже действенен. Для этого необходимо добавить свежий виноградный сок, либо немного сахара, для того, чтобы запустить повторный процесс брожения.
Профилактика и избавление от плесени на вине
Серная кислота — смерть винному грибку. Пустую емкость (сусло) перед заливом недавно сцеженного вина, необходимо при помощи серного фитиля окурить, что убьет весь грибок. Метод не сложный, но не у каждого есть такая возможность.
Добавление водки, спирта или же винного спирта. Данный метод позволяет стабилизировать градус напитка, и не дает грибку возможность размножаться. Стоить заметить, часто домашнее вино покрывается плесенью, если его градус ниже 12 процентов.
Пастеризация вина — метод хлопотный, но действенный. Для этого необходимо вымыть и стерилизовать бутыль над паром в течение нескольких минут, после чего бутыль закрывают стерильной крышкой и дают остыть до комнатной температуры. В это время, емкость, в которую было слито вино, погружают в более широкую кастрюлю с водой (перед этим на дно кладут деревянную подставку) и нагревают до 70 градусов. После чего дают чуть остыть, открывают бутыль и быстро переливают нагретое вино. Желательно закрывать стерильным гидрозатвором.
Симптомы инфекции на виноградной лозе
Серая гниль интенсивно размножается на листьях винограда, лозе и плодах и имеет свои признаки поражения в зависимости от зоны дислокации:
- Листья: появляются бурые, покрытые легким серым налетом пятна. С наступлением сухой и жаркой погоды пятна превратятся в ожоги, а сами листья отпадут. Сначала инфекция покрывает листья винограда, и только со временем расползается по всей лозе, поражая ее.
- Молодые побеги: новый прирост отмирает, лоза теряет силу. Некрозные побеги имеют бурый оттенок с легким налетом в виде пушка. Инфекция приводит к засыханию веток.
- Соцветия: в период формирования бутонов растение, пораженное гнилью, сбрасывает кисти. Они приобретают бурый цвет и засыхают. Как и на листьях сначала появляются пятна, которые расползаясь поражают всю часть растения.
- Гроздья: инфицирование серой гнилью этой части растения невозможно спутать с иным заболеванием. Как только грибок поразил плодоножку гроздь перестает развиваться, а сами плоды сначала вянут, лопаются, а затем засыхают. Если на ягодах винограда появилась бурая пятнистость необходимо провести профилактическое опрыскивание и удалить загнившие плоды, пока они не начали лопаться.
Плесень в вине при брожении — что делать
Можно убрать плесень посредством термической обработки напитка. Свойства плесени Botrytis влияют на вкусовые и структурные качества зараженных ею плодов. При желании сделать сладкие вина, используется сушильня, где происходит выпаривание влаги с плодов винограда, при этом остается кислотный концентрат и сахар. Благородный грибок, питаясь этими остатками, преобразует и раскрывает для любителей экзотики новые вкусовые гаммы.
Правда испортить процедуру производства может появление вредоносного грибка. Как бы ни хотелось, но страховки от появления плесени на винном сусле нет. Когда появился белый налет на вине, необходимо действовать. Ведь появление плесени на поверхности говорит о нарушении производства домашнего вина и заражении его микроорганизмами способными погубить творение. В чем опасность этого грибка?
Размножаясь в сусле, он преобразует его в воду и углекислоту. Расстраиваться не стоит, так как при правильном и быстром реагировании на возникшую проблему, напиток можно спасти.
Для начала надо установить степень поражения сусла:. В чем причина появления плесени, необходимо выяснить и обезопасить себя от повторений, для сохранения продукта своих трудов.
Сейчас этот форум просматривают: Google и гости: 0. Мой профиль.
Рекомендуем прочитать — Правда ли, что плесень опасна и приводит к онкологии? Когда появилась цвель плесень на вине , необходимо срочно приступать к спасательным работам.
Причины и признаки заплесневения браги
Ведь плесень в домашнем вине начинает съедать кислоту и сахар, преобразуя сусло в воду и углекислоту, как уже говорилось выше, чем портит напиток, созданный своими руками. Появление плесени при брожении в вине бывает в таких случаях:. Именно эти две возможные причины являются основными факторами для появления грибковых микроорганизмов в алкогольной продукции.
Для процесса приготовления вина и исключения плесени существуют правила, которые требуют их выполнения:. Даже когда вино покрылось плесенью не стоит впадать в панику. На начальном этапе ее развития необходимо выяснить, почему портится и плесневеет домашнее вино, устранить причину и последствия заболевания.
Основные симптомы, служащие сигналом о заболевании вина:. Поэтому для сохранения качества продукта необходимо знать, что делать, если на домашнем вине появилась плесень и как спасти напиток.
Рекомендуем прочитать — Предупрежден — значит вооружен! Какая плесень самая опасная?
Если вино начало плесневеть значит, была нарушена технология приготовления и хранения винного сусла. Для того что бы понять как спасти вино от плесени, необходимо выявить причину ее появления.
Способ избавления от плесени
В первую очередь, провести осмотр винного продукта и выяснить возможные очаги грибковой болезни гнилостное состояние осадка. Убрать плесень с домашнего вина можно, придерживаясь рекомендаций:. При наличии грибковой флоры в сусле, появляется и легкий запах плесени. Чтобы убрать запах плесени с домашнего вина используют два варианта:. Необходимо помнить, что качественный продукт, возможно, получить только при соблюдении технологии изготовления, соблюдением гигиенических норм и стерилизации способствующих предметов.
В этом случае Вам не грозит болезнь вина. Перейти к контенту ГРИБОК НА ТЕЛЕ Симптомы и лечение ушного грибка у человека Основные формы аспергиллеза у взрослых и детей и способы лечения Способы диагностики и лечения грибка в кишечнике Как вывести грибок из организма народными средствами Эфирные масла от грибка на ногах подборка, рекомендации по применению К чему может привести обычное наращивание ногтей Йод от грибка: лучшее средство на начальной стадии заболевания Нет лучше средства от грибка ногтей, чем сода!
Советский способ избавления от грибка ногтей с помощью дегтя Есть в каждом доме и стоит копейки! Основные разновидности Эффективен ли лазер при грибке? Обычная простуда или грибок в носу: как распознать? Страдаете аллергией и не можете вылечить грибок? О каких проблемах со здоровьем говорит грибок ногтей? Эти таблетки вылечат грибок! Сок скорее розовый. Решил делать через подброженную мезгу, размял прямо с черенками, не мыл, на диких дрожжах решил, сложил в пластиковое ведро, сверху закрытое тканью как советовалось в каких то инетных рецептах и в скороварку из нержи.
Как на зло, батареи отключили в это время, в квартире стояла температура около 20 С. Есно не бродило, грел у масляного обогревателя. Сегодня третий день,забродило, но посмотрев внутрь, с ужасом увидел островки зеленой плесени на поверхности массы. И в ведре, и в скороварке. Снял ее, но конечно же все пропало, так?
Как избежать образования плесени при приготовлении вина в домашних условиях
Как известно, любую проблему проще предотвратить, чем решать ее в будущем. Это же правило работает и относительно винной плесени. Следование простому набору рекомендаций убережет ваш напиток от появления этой неприятной субстанции.
Уделите особое внимание процессу перебирания плодов. Помните, что даже один испорченный фрукт или ягода может привести к тому, что вся партия вина окажется испорченной
Также проследите, чтобы все емкости были продезинфицированы. Обдайте их кипятком и только после этого добавляйте внутрь сусло. При брожении на мезге, а не на соке, обязательно в первые дни перемешивайте содержимое бродильной емкости чистой ложкой. Утапливая мезгу каждый два часа вы предотвратите появление на ней плесени. Не забывайте, что гидрозатвор и резиновая перчатка это не просто приспособления для отслеживания процесса брожения, в первую очередь это барьер. Они не позволяют спорам грибка попадать внутрь. Значительное разбавление сусла водой снижает концентрацию дрожжей, а также уменьшает кислотность. Все это, как мы знаем, зачастую приводит к появлению плесени. Хранить и настаивать готовое вино следует сугубо в прохладном месте и с плотно закрытой пробкой. Эти меры позволят избежать попадание болезнетворных грибков внутрь тары.
Как видите, плесень в вине при брожении не является чем-то необычным или фатальным. Если вовремя отреагировать на ее появление и принять правильные меры вы вполне сможете спасти свой напиток, причем получится он таким же качественным.
Предотвращаем появления плесени
- Для этого необходимо избегать попадания в сусло спор грибков.
- Тщательное стерилизовать инструменты, приборы, пробки, которые участвуют в процессе приготовления напитка. По мимо этого неотъёмным условием работы с вином является наличие чистых рук.
- Нельзя использовать для приготовления напитка плесневелых или гнилых ягод. Если вы приняли решение не отделять мякоть и кожицу от сока, то есть брожение создать на мезге, тогда нужно перемешивать так верхний слой, чтобы не допускать длительного контакта кислорода и мезги.
- Чтобы поддержать нужную кислотность не нужно сильно разбавлять сусло водой. По мере необходимости можно добавлять лимонную кислоту.
- Устраняйте возможности проникновения в напиток кислорода, для этого устанавливайте гидрозатвор и убедитесь в герметичности.
- Храните напиток после брожения при температуре 10-16 С.
Но в случае, когда вино заражается плесневыми грибками, на начальной стадии приготовления, то вылечить его уже нельзя.
Нашли ошибку? Выделите ее и нажмите Shift + Enter или нажмите здесь
















































